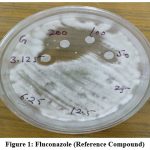
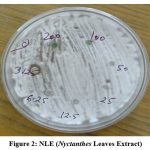
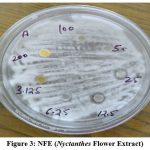
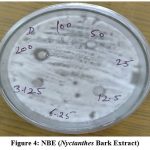
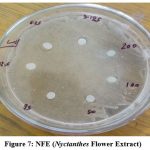

Introduction
In addition to therapeutic substances, medicinal plants are a great spring of knowledge far reaching and inclusive range of mixture compounds that might be created like medications in the company of exquisite preference1. A little sacred ornamental and medicinal tree called Nyctanthes arbor-tristis is well-known throughout the nation for its sporadic white blossoms. Night jasmine or parijata is the common name of the plant. Along with its use in the Ayurvedic, Sidha, and Unani medical systems in India (Orissa and Bihar), different portions of Nyctanthes arbor-tristis are known to possess a variety of diseases3. Herbs, which are today the subject of intensive scientific study, are used in Indian traditional medicine. The majority of plant-produced chemicals are toxic to bacteria.4 The current study set out to determine how susceptible different disease-causing bacterial and fungal strains were to various solvent extracts of Nyctanthes arbor-tristis leaf material.
The development of off-flavors and the production of allergenic substances are both caused by the development of fungi that are harmful to crops5,6. The most major fungus reducing small grain corn output and tainting foods produced from it are Aspergillus, Fusarium, and Penicillium species. Fungal infection can be controlled using a variety of tactics, from the embrace of particular agricultural methods for the creation unaffected cultivars7. Insecticide is still one of the most crucial methods for reducing the frequency of plant diseases. To accomplish this and control the plant disease, a variety of chemical pesticides, including some sulphur compounds, and oxidizing agents, has been developed over the past few years. Natural products from higher plants may offer a new supply of antibacterial substances with possibly distinct mechanisms of action.8,9 A huge number of researchers from all around the world have investigated how plant extracts affect bacteria.8 India has seen a lot of research into ethnomedical herbs.10
Methodology
Plant material collection
Nyctanthes arbor-tristis Leaves, Bark and Flowers were collected from the different places Shikohabad, Trans Yamuna colony and Agra in the year of 2021. The Flowers were collected in the month of September to November 2021.
Preparation of Plant Extract
The Nyctanthes leaves, bark, and flowers were removed following accepted best practises.11The plant components were mechanically ground into powder after being dried in the shade. Using a Soxhlet extractor, the plant material powder (25.0 g) was first defatted for 48 hrs lower than the boiling point of the solvent using an ethanol solvent (60–80°C). The extracts were filtered while still hot using Whatman filter paper (No. 1), and it was concentrated under decreased pressure and vacuum using a rotary flask evaporator before being desiccated.4.20 gm of dark greenish solid residue was produced. This extraction technique produced higher extract yields. Then, the extracts were kept for future use, in sterile vials in a cool atmosphere. By evaporating the solvent, the plant extracts were made dry, and the dry weight was used to calculate the concentration in mg/ml. The extract was kept at a low temperature2. The possibility for having antibacterial activities was further investigated using these crude extracts of Nyctanthes plant.
Test microorganism and growth media
Pseudomonas aeruginosa, a bacterial strain, and Penicillium expansum, a fungal strain, were chosen due to their clinical and pharmacological significance.12 The Dr. B.R. Ambedkar University’s Khandari Campus Department of Microbiology provided the bacterial strains that were used to test the antibiotic activity. Following cooling storage at, on nutrient agar and sabourod dextrose agar (SDA) medium, the bacterial and fungal stock cultures were grown for 24 hours at 35°C, respectively. The bacteria were cultivated in nutritional broth at 35°C and kept on nutrient agar slants at cold condition before being cultured on Nutrient agar plates., whereas Penicillium expansum was grown in Sabouraud dextrose agar medium, respectively, at 27°C. The stock cultures were stored at room temperature.
Microbial Assay
Antimicrobial assay
With a glass spreader, 0.1ml of a fresh microbial culture was applied to a nutrient agar plate. The petri plates were then incubated in an incubator at 37 °C for 24 hours after being placed in a refrigerator for 30 minutes to allow pre-diffusion of the extract. The zone of inhibition was measured to assess the antimicrobial screening. Extracts from Nyctanthes were tested for their in vitro antibacterial and antifungal effects. The agar disc diffusion method was used to examine the antibacterial and antifungal properties of plant component extracts against Pseudomonas bacteria and Penicillium fungus.13-15 The antibacterial and antifungal effects of each extract were evaluated against the bacteria Pseudomonas aeruginosa and the fungus Penicillium expansum. Using nutrient agar tubes, sets of seven dilutions of Nyctanthes extract and standard medications (200, 100, 50, 25, 12.5, 6.25, and 3.125 µg/ml) were made. Indicator bacterial strains were planted on nutrient agar plates, which were then kept at 37oC for three hours. Fluconazole, which has antifungal properties, and cefixime, which has antibacterial properties, were used as standard medications in control studies carried out under comparable circumstances. By measuring the sizes of the inhibitory zones (including the diameter of the disc) on the agar surface around the discs, it was possible to assess how sensitive the various microbe species were to the plant extracts.
Antibacterial assay
For the purpose of evaluating the antibacterial activity of plant extracts24, the disc diffusion method was used. Overnight, the bacterial strain was raised in nutrient broth at 28 °C. A thick grass was created on the Nutrient agar plate using the Pseudomonas aeuriginosa inoculum (100 µl). Then, 30 µl of the plant extract sample were impregnated into a paper disc. Plant extracts were diluted in concentrations of 200, 100, 50, 25, 12.5, 6.25, and 3.125 µg/mL. The clear zone of inhibition that surrounded the discs were measured in mm (diameter).
Antifungal assay
For the purpose of evaluating the antifungal activity of plant extracts24, the disc diffusion method was used. Overnight, the bacterial strain was raised in nutrient broth at 28 °C. A thick grass was created on the Sabourod Dextrose Agar plate using the penicillium expansum inoculum (100 µl). Then, 30 µl of the plant extracts sample were impregnated into a paper disc. Samples were diluted in concentrations of 200, 100, 50, 25, 12.5, 6.25, and 3.125 µg/mL. The clear zone of inhibition that surrounded the discs were measured in mm (diameter).
Results and Discussion
Antifungal activity of Nyctanthes plant extract
The maximum zone of inhibition found at 200µg/ml concentration is 12mm in NBE (Nyctanthes Bark Extract), 10mm in NLE (Nyctanthes Leaves Extract) and 7mm in NFE (Nyctanthes Flower Extract) plant extract. Highest zone of inhibition found in Nyctanthes bark extract that was 12mm nearest fluconazole compound.
|
Figure 1: Fluconazole (Reference Compound) |
|
Figure 2: NLE (Nyctanthes Leaves Extract) |
|
Figure 3: NFE (Nyctanthes Flower Extract) |
|
Figure 4: NBE (Nyctanthes Bark Extract) |
Plate shows Antifungal activity of Nyctanthes Plant
Table 1: Antifungal Activity – Inhibition Zone (Mm).
| CONCENTRATION µg/ml | REFERENCE | NLE | NBE | NFE |
| 200 | 24 | 10 | 12 | 7 |
| 100 | 14 | 5 | 5 | 7 |
| 50 | 11 | 5 | 8 | 5 |
| 25 | 12 | 5 | 5 | 8 |
| 12.5 | 5 | 5 | 7 | 9 |
| 6.25 | 6 | 6 | 6 | 7 |
| 3.125 | 5 | 9 | 8 | 6 |
Antibacterial Activity
Antibacterial activity of Nyctanthes plant extract
The maximum zone of inhibition found at 200µg/ml concentration is 14mm in NFE, 10mm in NLE and 13mm in NBE plant extract. Highest zone of inhibition found in Nyctanthes flower extract that was 14mm nearest reference compound cefixime antibiotic.
 |
Figure 5: Reference compound (Cefixime Antibiotic) |
 |
Figure 6: NLE (Nyctanthes Leaves Extract) |
|
Figure 7: NFE (Nyctanthes Flower Extract) |
 |
Figure 8: NBE (Nyctanthes Bark Extract) |
Plate shows antibacterial activity of Nyctanthes Plant
Table 2: Antibacterial Activity – Inhibition Zone (Mm).
| CONCENTRATION µg/ml | REFERENCE | NLE | NBE | NFE |
| 200 | 18 | 10 | 13 | 14 |
| 100 | 12 | 8 | 9 | 13 |
| 50 | 8 | 7 | 7 | 12 |
| 25 | 7 | 6 | 6 | 11 |
| 12.5 | 5 | 5 | 5 | 9 |
| 6.25 | 5 | 5 | 5 | 8 |
| 3.125 | 5 | 5 | 5 | 6 |
Conclusion
The development of microbial resistance to the available antimicrobial medicines is mostly to blame for the fact that microbial infections have recently grown to be a substantial clinical danger with significant associated morbidity and mortality.
Many experts from all around the world were looking into the antibacterial properties of various plants. Nyctanthes arbor-tristis leaf extracts in ethanol solvents have antibacterial properties. The aforementioned finding indicates that certain plant species’ leaf extracts have the ability to serve as antimicrobial agents against pseudomonas bacteria and can be used to treat infectious disorders brought on by a variety of germs. The results of the aforementioned experiment lead us to the conclusion that the ethanol extracts of the flower extracts exhibited the strongest antibacterial activity. Many experts from all around the world were looking into the antibacterial properties of various plants. Nyctanthes arbor-tristis leaf, bark and flowers in various solvents have antibacterial properties.15 The aforementioned finding indicates that certain plant species’ leaf extracts have the ability to serve as antimicrobial agents against bacteria and can be used to treat infectious disorders brought on by a variety of germs. We can infer from the aforementioned experiment’s findings that the ethanol extract of the flowers had the highest antibacterial activity. Pseudomonas aeruginosa, which can cause infections in the blood, lungs (pneumonia), or other parts of the body after surgery.
The aforementioned finding indicates that certain plant species leaves, bark and flowers extracts have the ability to serve as antifungal agents against Penicillium fungus and can be used to treat infectious disorders brought on by a variety of fungi16. The results of the aforementioned experiment lead us to the conclusion that the ethanol extracts of the bark exhibited the strongest antifungal activity.
Acknowledgement
Authors thankful to microbiology department for microbial activity, school of life sciences Khandari campus, Dr. B. R. Ambedkar University, Agra for his constant encouragement and support for this research.
Conflict of interest
The authors declare no conflict of interest.
References
- Vijyalakshmi R, Ravindran R, Preliminary comparative phytochemical screening of root extracts of Diospyrus ferrea (Wild.) Bakh and Arva lanata (L.) Juss. Ex Schultes. Asian J Plant Sci Res 2012, 2:581-587
CrossRef - Nadkarni AK, Indian Materia Medica, Vol.I, 3rd ed. (Popular Prakashan Pvt. Ltd.,) 1982, 857-858.
- Singh B, Bhat TK, Bhupender S, Potential Therapeutic Application of Some Antinutritional Plants Secondry Metabolite. Journal of Agriculture Food Chemical; 2003, 51:5579-5597
CrossRef - V. Nielsen and R. Rios, “Inhibition of fungal growth on bread by volatile components from spices and herbs, and the possible application in active packaging, with special emphasis on mustard essential oil,” International Journal of Food Microbiology, vol. 60, no. 2-3, 2000. 219–229.
CrossRef - Bhatnagar and S. P. mc Cormick, “The inhibitory effect of neem (Azadirachta indica) leaf extracts on aflatoxin synthesis in Aspergillus parasiticus,” Journal of the American Oil Chemists’ Society, 1988, vol. 65, no. 7, pp. 1166–1168.
CrossRef - Terzi, G. Tumino, A. M. Stanca, and C. Morcia, “Reducing the incidence of cereal head infection and mycotoxins in small grain cereal species,” Journal of Cereal Science, vol. 59, no. 3, 2014, 284–293.
CrossRef - Runyoro D, Matee M, Olipa N, Joseph C, Mbwambo H. Screening of Tanzanian medicinal plants for anti‐Candida activity. BMC Complement Altern Med 2006; 6:11.
CrossRef - Shahidi BH. Evaluation of antimicrobial properties of Iranian medicinal plants against Micrococcus luteus, Serratia marcescens, Klebsiella pneumonia and Bordetella bronchoseptica. Asian J Plant Sci 2004; 3:82-6.
CrossRef - Reddy PS, Jamil K, Madhusudhan P. Antibacterial activity of isolates from Piper longum and Taxus baccata. Pharmaceutical Biol 2001; 39:236‐8
CrossRef - Harborne JB. Phytochemical methods: A guide to modern techniques of plant analysis. Chapman and Hall, Newyork 1973: p-279 19
CrossRef - McCracken WA, Cowsan RA. Clinical and Oral Microbiology. New York: Hemispher Publishing Corporation; 1983. p. 512
- Alzoreky NS, Nakahara K. Antibacterial activity of extracts from some edible plants commonly consumed in Asia. Int J Food Microbiol 2003; 80:223-30.
CrossRef - Bauer AW, Kirby WMM, Sherris JC, Turck M. Antibiotic susceptibility testing by standardized single disc method. Am J Clin Pathol 1966; 36:493-6.
CrossRef - Rios JL Recio MC, Villar A. Screening methods for natural products with antimicrobial activity: A review of the literature. J Ethnopharmacol 1988; 23:127-49.
CrossRef - Paikara et al.: “Antimicrobial activity of Nyctanthes arbor-tristis” Indian J.L.Sci. 5(1): 029-032, 2015
- Mali S.C. et al., “Green synthesis of copper nanoparticles using Celastrus paniculatus Willd. leaf extract and their photocatalytic and antifungal properties,” Biotechnology Reports 27 (2020) e00518
CrossRef

